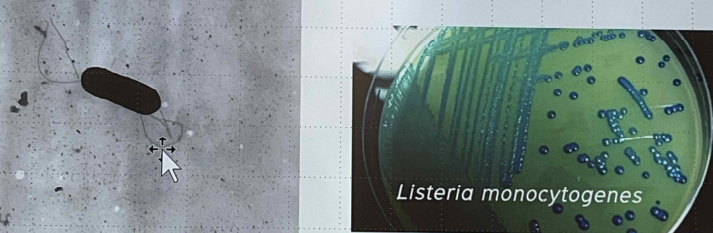

๊ตฌ๊ฐ๊ท (coccobacillary rod)
- ๊ทธ๋ ์์ฑ์ coccobacillary rod(๊ตฌ๊ฐ๊ท )
- flagella๋ฅผ ๊ฐ์ ธ ์ด๋์ฑ์ด ๋์. ์ธํฌ์ ๋ฐ๊นฅ์์๋ ์ด๋์ฑ์ด ์์ง๋ง ์ธํฌ ๋ด์ ๋ค์ด๊ฐ๋ฉด ๋งค์ฐ ๋น ๋ฅธ ์๋๋ก ๋์๋ค๋.
- ์กฐ๊ฑด ํ๊ธฐ์ฑ, ํ์ฒญ์์ ๊ฐ๊น์ด colony
Listeria monocytogenes
- 6์ข ๋ฅ์ Listeria ๊ท ์ค ๊ฐ์ฅ ์ค์ํ ์ข ๋ฅ, ๊ฑฐ์ ๋๋ถ๋ถ์ ๊ฐ์ผ์ ๋ด๋น
- ์๋ ์ ์๋ ์จ๋ ๋ฒ์์ pH ๋ฒ์๊ฐ ๋งค์ฐ ๋๋ค. : 4
45โ, pH 5.59.6 - ์ํฌ(spore)์ ํ๋ง(capsule)์ด ์๋ค.
- ์ฆ์ : mastitis, abortion, circling, microabscess, septicemia, endothalmitis
- ์๊ธฐ flagella๊ฐ ์๋๋ผ, ์์ฃผ์ microfilament๋ฅผ ์ด์ฉํด ์ด๋^[์๊ธฐ๋ flagella ๊ฐ์ง, ๊ทธ๋ฌ๋ ์์ฃผ ์์์๋ ์์ฃผ ๊ฑฐ ์!]
Listeria species์ differentiation
- ํ์ฒญํ 16์ข ๋ฅ
- DNA probe assay
- DNA fingerprinting
๋ฐ๋ณ
- ์ฅ์ M cell์ transcytosis โblood๋ฅผ ํตํด ํ์ฐ โsepticemia(ํจํ์ฆ) ํ encephalitis(๋์ผ)
- ๊ตฌ๊ฐ, ๋น๊ฐ ์์ฒ๋ฅผ ํตํด ๊ฐ์ผ โ ๋๊ต, ์ฐ์ ๋ฑ brain stem์๊น์ง ์ ๊ฐ์ผ๋จ
- ์์ ํ ๊ฐ์ถ์์๋ abortion(์ ์ฐ)
- perivascular lymphocytic Cuff (ํ๊ด ๋ดํผ์ธํฌ ๋ฐ๊นฅ์ผ๋ก ์ธ๊ท ์ด ์ญ ๋ฌ๋ผ๋ถ์)
Invasion
- ํ์์ธํฌ/๋นํ์์ธํฌ ๋ชจ๋ ๊ฐ์ผ
- internalins๋ฅผ ์ด์ฉํด์ ๋ถ์ฐฉํ์ฌ ์ธํฌ ๋ด๋ก ๋ค์ด๊ฐ
- ์ธํฌ ๋ด์์ ํ๋ฐํ๊ฒ ์ฆ์
- ์ธํฌ๋ฅผ ํ๊ดดํ์ง ์๊ณ , ์ธ์ ํ ์ธํฌ๋ฅผ ๋ฐ๊ณ ๋ค์ด๊ฐ๋ฉฐ ์ ํ
- ์ธํฌ ์์ชฝ ๋ง์ ์ ์ดํ์ฌ pseudopod-like projections ํ์ฑ (์ธํฌ๋ง ๋ณผ๋กํ๊ฒ ๋ณํ)

Listeriosis in ruminants
-
4๊ฐ์ง ์ฃผ์ ์ฆ์ : ๋์ผ, ์ ์ฐ, ํจํ์ฆ, ์๊ตฌ๋ด์ผ(endophthalmitis)
-
๊ฒจ์ธ์ฒ , ์ด๋ฅธ ๋ด์ ๋ง์ด ๋ฐ์
-
silage(๋ชฉ์ด)๋ฅผ ๋จน๊ณ ๋ง์ด ๋ฐ์
-
cell-mediated immunity๊ฐ ๋จ์ด์ง ์์ ํ ๊ฐ์ฒด์์ susceptability๊ฐ ๋๋ค
clinical signs
- neural listeriosis
- ๋ํ์ ์ธ ์ฆ์์ด circling disease-ํ์ชฝ ๋ฐฉํฅ์ผ๋ก ๋น๊ธ๋น๊ธ ๋๋ค
- dullness(๋๊ฐ, ๋ฉ์ฒญ), circling, tilting(๋จธ๋ฆฌ๋ฅผ ํ์ชฝ์ผ๋ก ๊ธฐ์ธ์)
- unilateral facial paralysis : ๊ท๊ฐ ๋์ด์ง, ๋๊บผํ ๋ง๋น, ์นจ์ ์ง์ง, ๋จธ๋ฆฌ ๊ธฐ์ธ์ธ ์ชฝ์ด ์ ๋ฐ์ ์ผ๋ก ๋ง๋น
- ๊ฐ์ผ ์ด๊ธฐ์ ์ฒด์จ ์์น
์น๋ฃ
- ์ด๊ธฐ ๋จ๊ณ : ampicillin๊ณผ amoxicillin
- ์ด๋ ์ ๋ ์งํ๋ ์ดํ์๋ ํฌ๊ฒ ์น๋ฃ ํจ๊ณผ X
- ๋์ ๊ฐ์ผ๋๋ฉด(ocular listeriosis) - ๋์ ํญ์์ ๋ฅผ ์ ์
์ธ์๊ณตํต์ ์ผ๋ณ
๊ฐ์ผ ๋ฃจํธ
- ๋๋์ ํ ์๋ชป ์ญ์ทจ
- ๋๋ถ๋ถ ๊ณ ์จ์ด๊ท ๋ฒ์ผ๋ก ์ฒ๋ฆฌ๋ ์ฐ์ ์ธ๋ฐ, pasteurization์ผ๋ก ์์ ํ ์ ๊ฑฐ๋์ง ์์